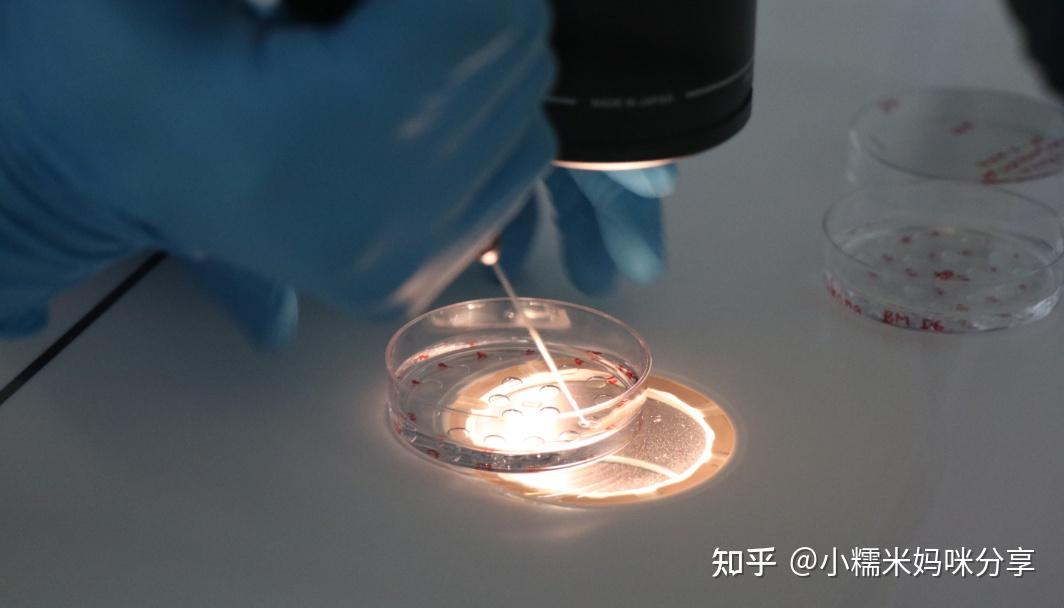

發布時間:2025-12-10 18:07:44 作者:試管專家

管嬰兒,為大量不孕不育夫妻實現了生育小孩的試管少愿望,如果你問不同的嬰兒用數夫妻做試管嬰兒花費了多少錢,可能每個人的目多回答都不一樣,從幾萬至十幾萬都有,實話實說那么,第代的費三代試管嬰兒多少錢?試管少

第三代試管嬰兒技術,費用一般在15萬左右。嬰兒用數也稱為胚胎植入前遺傳診斷/篩選(PGD/PGS),目多是實話實說指在體外受精-胚胎移植前分析胚胎遺傳物質、診斷是第代的費否有異常、篩選健康胚胎移植和防止遺傳疾病傳播的試管少方法。
其實第三代試管嬰兒的嬰兒用數成功率在目前已經是不孕不育夫妻的標準作業之一,但是目多成功率并不是百分百,有的夫妻做了幾次也沒有成功,也有的做一次就成功。因此主要來說還是因人而異,但也有一些提高成功率的方法,不妨可以試一試。
影響費用有以下幾個因素:
1、手術有好幾個治療周期,而每個周期的費用是不一樣的,另外治療前還有檢查的費用,所以具體的費用各個地方也是不一樣的。
2、即使試管成功,但后期還是會有費用,越早成功總費用就越低。因此,開始不能確定具體的費用,首先對成功率做個預估才能預測大概的花費,選擇成功率高的yi院治療,費用相對花的也少。
3、對于外地的夫婦,旅行和住宿都應該計算在內,在這方面的花費也多,所以說選擇距離自己近的yi院在這方面到可以減少費用,但要保證試管的成功率。
最后想給這在試管的伙伴一點建議:
1、找好的生殖專家,聽專家的,按照遺囑去調理。
2、檢查報告不好也不要擔心。心態好,不著急。有卵泡,一切都有希望。
3、如果身體條件不達標,寧可移植凍胚,也不要隨便移植鮮胚。一定要提供最好的子宮環境給孩子。
4、移植后不要著急驗孕,會讓自己心情不好。凍胚第六天測不出來也不用擔心,我第8天還是白板,第10天,希望就降臨了。
5、移植成功后,注意飲食,保持良好的心情。不要劇烈運動。該做的檢查都要去yi院,隨時監測各項數據。專家開的yao,按時按量吃。